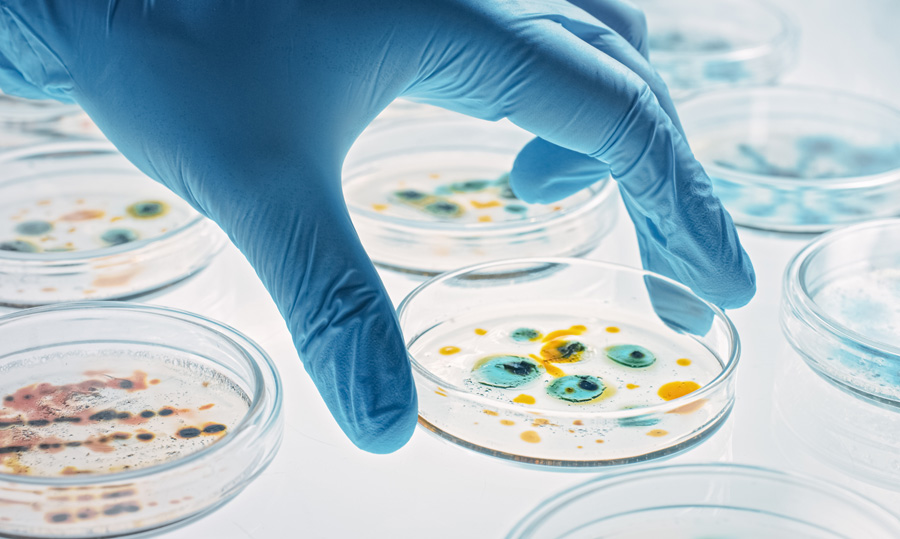

Our work in 2020
2020 in brief
The COVID-19 pandemic is the most extensive Public Health Event (PHE) ECDC has had to respond to since the Centre became operational in 2005. In 2020, supporting the EU COVID-19 response became indeed the dominant activity of the Centre.
Get informed for 2020 in briefECDC public health functions: main achievements
ECDC disease programmes: main achievements
From 1 January 2020, ECDC is organised in four permanent Disease Programmes (DPs):
- The Antimicrobial Resistance and Healthcare-Associated Infections (ARHAI) Programme;
- The Emerging Food and Vector-Borne Diseases (EFVED) Programme;
- The STI, Blood-Borne Viruses and TB (SBT) Programme;
- Vaccine Preventable Diseases and Immunisation (VPI) Programme.
During the year, a fifth temporary disease programme, the COVID-19 and Influenza (CAI) Programme was set up to address all non-urgent issues related to COVID-19 and influenza not covered by the first line PHE organisation and other organisational entities.
Learn about our Disease programmes